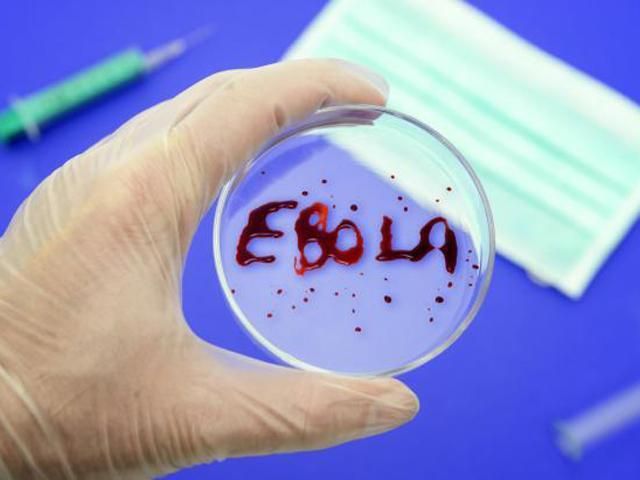
Вірус Ебола вже забрав життя майже 7 тисяч людей Вірус Ебола вже забрав життя майже 7 тисяч людей

Кількість заражених - 16 тисяч 169 людей.
Найбільша кількість заражених вірусом зафіксовано в Ліберії - 7 тисяч 244 людей. У цій країні померли 4 тис 181 осіб.
У Сьєрра-Леоне вірусом Ебола заразилися 6 тисяч 802 людини, а померли - 1 тисяча 463 інфікованих.
У Гвінеї кількість заражених складає 2 тисячі 123 людини. Від вірусу померли 1 тисяча 284 людини.
Нагадаємо, вакцина проти лихоманки Ебола була успішно випробувана на людях.